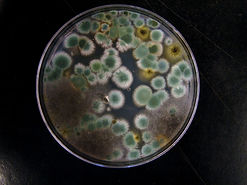
5613736457_47a30a9265_b.jpg

Investigating pheromone-mediated hygienic behaviors and antimicrobial properties in Linepithema humile

University of Florida
Fall 2025 Semester (16 weeks)
PI: Dr. Elizabeth Cash
Funding awarded through University of Florida University-scholars-program.
The University of Florida, Entomology & Nematology Dept., The University of Florida, Engineering School of Sustainable Infrastructure & Environment.
The Argentine ant is a highly invasive species with significant economic and environmental impacts, and is ranked among the top 100 most damaging invasive species. In addition to being unicolonial and highly polygynous, an important feature of L. humile’s invasive success is their trail pheromone, which is known to have many functions including path recognition, alarm signaling, death cues, and defense against competitors. Previous work has shown that this pheromone is primarily composed of two iridoid chemicals, iridomyrmecin and dolichodial, and is biosynthesized via a specialized exocrine gland called the pygidial gland. These chemicals are then stored in two large, internal reservoirs and excreted from a pore at the posterior end of the workers’ abdomen. A recent, ongoing study of microbes sampled from invasive Argentine ant nests and the surrounding environment showed that one component of L. humile’s trail pheromone, dolichodial, exhibits broad antimicrobial properties, supporting the hypothesis that Argentine ants may be using these pheromones as part of their individual and social hygiene. Little is known, however, about its efficacy against known insect pathogens, e.g., entomopathogenic fungi, or about the behavioral mechanisms involved in its use.
To further investigate these open questions, research methods will include: (1) behavioral assays to study how ants are using pheromones for social hygiene, (2) pheromone extraction to collect and test pheromone function, (3) gas-chromatography/mass spectrometry (GC/MS) to qualitatively and quantitatively assess pheromone presence and abundance in the context of hygienic behaviors, and (4) fungal culturing to assay the antimicrobial effects of trail pheromone chemicals against known entomopathogens. By understanding the hygienic behavior of these highly invasive ants, we can better characterize the features that contribute to their invasive success and begin to study alternative forms of biological control.